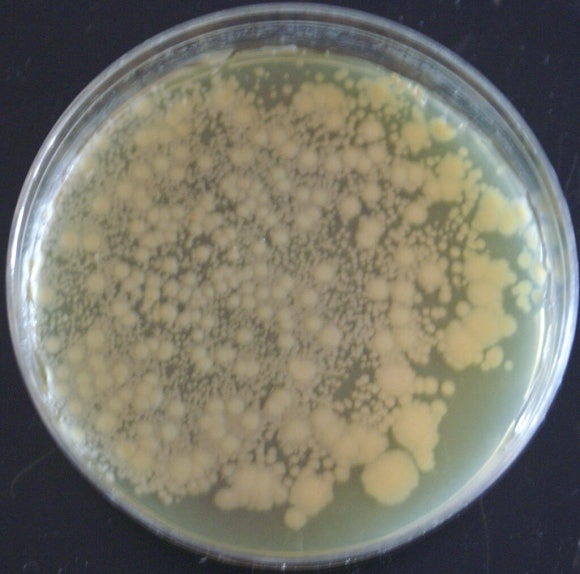

Home - SCIENCE WAVE
사이언스 웨이브(Science Wave)는 과학의 눈으로 세상을 바라봅니다. 최신 과학뉴스와 쉽고 재미있는 과학상식을 전달합니다.
sciencewave.kr
뉴스에 자주 등장하는 유전자변형생물 즉 GMO(genetically modified organism)란 유전자공학 기술을 활용하여 유전자의 분자 구성을 변형시키는 방법으로 만든 새로운 생물 종이나 변종을 말한다. GMO는 인위적으로 돌연변이를 일으켜 육성한 생명체이기 때문에 위험한 생물체가 탄생하게 될 가능성도 있지만, 현재까지 과학자들은 인류의 생존에 매우 유리한 GMO를 만들어 오고 있다. <본사 블로그 검에서 '돌연변이' 참고>
농업인들에게 가장 힘든 일의 하나는 농토에 자라는 잡초를 제거하는 것이다. 제초제를 살포하면 작물까지 죽어버린다. 그러나 약 30년 전인 1996년 미국의 유명 종자회사 몬산토(Monsanto)사의 과학자들은 제조제를 뿌려도 죽지 않고 잘 자라는 GMO 옥수수 종자를 만들었다. 그에 따라 광대한 면적에서 기계로 옥수수를 재배하는 농업인들은 제초제를 살포해도 수확량에 지장을 받지 않으면서 옥수수를 경작하게 되었다. 오늘날 재배되는 GMO 농작물에는 옥수수 외에 콩, 목화, 감자, 파파야, 유채, 사료작물인 알팔파, 채소류 등이 있다.
그간 유전공학자들이 만든 대표적인 GMO에는 다음과 같은 것들이 있다.
1- 생장 속도가 빠르고 영양가가 더 좋으며 병충해에 강한 작물
2- 당뇨병 환자의 혈당치를 내려주는 인슐린을 대량 생산하는 미생물 GMO
3- 정상적으로 키가 자라지 못하는 청소년의 성장에 도움이 되는 호르몬을 효과적으로 생산하는 미생물 GMO
4- 발효식품을 더 맛있고 효과적으로 생산하도록 하는 미생물 GMO
GMO는 인체에 안전한가?
뉴스에서는 GMO가 ‘인체에 위험할 수 있다’라든가 ‘괴물 생명체가 탄생할 수 있다’는 이야기가 나오기도 한다. 이런 위험성을 대비하여 과학자는 물론이고 각국의 정부기관(미국의 경우 농무성, 환경보호국, 식품의약국)은 인체와 환경에 피해를 주지 않는 GMO만 개발하도록 철저히 통제하고 있다.
인위적인 유전자 변형
과거에는 식물 또는 동물의 새로운 품종을 육성할 때 비슷한 종 또는 품종끼리 교잡하거나 돌연변이를 인위적으로 일으키는 방법을 사용했다. 그러나 유전자의 복잡한 화학적 성질과 구성을 자세히 알게 된 과학자들은 염색체 속에 길게 연결된 유전자 중의 특정 부위에 다른 생명체로부터 가져온 유용한 유전자를 인위적으로 집어넣어 새로운 종 또는 품종을 육성해낼 수 있게 되었다.
최초의 GMO는 1973년에 미국의 생명공학자 보이어(Herbert Boyer 1936)와 코헨(Stanly Cohen 1935)이 공동으로 육성한 ‘카나마이신’이라는 항생물질에 죽지 않는 박테리아 GMO를 만든 것이었다. 다음 해인 1974년에는 MIT의 생물학자 재니쉬(Rudolf Jaenisch 1942)가 유전자를 변형한 쥐를 만들었다. 이 GMO 쥐는 암 연구에 이용되고 있다.

유전자가 변형된 털색이 달라진 쥐(왼쪽)와 정상 쥐(오른쪽)의 모습이다.
1983년에는 처음으로 식물 GMO가 만들어졌다. 그것은 담배의 잎에 발생하는 세균에 대해 저항력을 가진 신품종이었다. 이런 내병성 담배는 살균제를 살포하지 않아도 건강하게 키울 수 있다. 그리고 2000년에는 비타민 A 함량이 특히 많은 벼 품종 골든라이스(golden rice) GMO가 탄생했다.

일반 쌀과 골든라이스를 비교한다. 비타민 A(베타 카로틴)가 많이 포함된 골든라이스는 베타 카로틴 때문에 황금색이다. 세계적으로 저개발국가에서는 비타민 A 부족으로 1년 동안에 5세 이전에 생명을 잃는 어린이 수가 67,000명 정도이고, 시력을 상실하는 어린이는 500,000명에 이를 것이라고 한다. 골든라이스의 보급은 그들의 건강을 지켜줄 수 있을 것이다.
미국의 유전공학회사인 지넨텍(Genentech)은 1978년에 대장균(E. coli)의 유전자 속에 인슐린 단백질을 생산하는 유전자를 삽입하여, 대장균이 당뇨병 환자를 치료하는 인슐린을 대량 생산하도록 하는 데 성공했다. 1982년부터 식품안전국의 허가를 받아 싼값의 귀중한 치료약이 된 대장균 인슐린은 humulin이라는 이름으로도 알려져 있다.
1994년에는 캘리포니아주에 있는 종자회사(Calgene)의 과학자인 세이버(Flavr Savr)가 곰팡이 병에 강하고 향기가 더 짙으며 저장 기간이 긴 토마토 GMO를 만드는 데 성공했다. 2003년에는 다양한 모양, 색 및 형광을 내는 물고기 GMO들이 연달아 만들어져 수족관에서 자라게 되었다.
또한 미국의 연어 양식회사(AquaBounty Technologies)에서는 연어 종류 중에 가장 크게 자라는 치누크연어의 특정 유전자를 대서양연어의 유전자에 이식하는 방법으로 3년 이상 자라야 성어가 되던 대서양연어를 16-18개월 만에 성어가 되도록 키울 수 있게 되었다. 이 연어 GMO는 1989년에 육성된 뒤, 2015년부터 양어장에서 대규모로 양식하여 식품화하도록 허가되었다. 유전자공학이 발달하면서 오늘날에는 다수의 유전공학회사가 많은 종류의 미생물, 식물, 동물 GMO를 생산하고 있다.


제브라피시는 인도가 원산지인 인기 있는 작은 열대어의 일종이다. 미국의 글로피시(GloFish)사는 제브라피시에 형광을 내게 하는 유전자를 집어넣어 다양한 색을 내는 형광 제브라피시를 만들어냈다. 위 사진은 자연의 제브라피시이고, 아래는 형광 제브라피시이다.

박테리아 종류는 실험실의 시험관 속에서 대량으로 간단히 배양할 수 있고, 몇 시간 또는 며칠 사이에 분열하여 빠르게 증식한다. 그러므로 과학자들은 박테리아를 이용하여 다양한 GMO를 쉽게 만들고 있다. 위 사진은 자연 대장균이고, 아래는 형광 단백질을 생산하는 유전자를 삽입하여 만든 형광대장균 GMO이다.

선토리(Suntory)사가 2004년에 유전자변형으로 만든 옅은 보라색 장미(blue rose)이다. 이 회사는 장미 외에 국화와 페튜니아 등에서도 여러 색을 가진 GMO 식물을 만들었다.
유전자를 변형하는 방법은 여러 가지이고, 구체적인 내용은 전문적이다. 오늘날에는 바이러스 GMO까지 만들고 있다. 바이러스 GMO는 작물에 병을 일으키는 세균을 죽이거나, 암 조직이 파괴하도록 하는데 이용될 가능성이 있다. 특히 병균에 강한 작물 GMO는 인류의 식량 증산에 큰 도움을 주고 있다.
-YS
우주에서 눈물을 흘리면 어떻게 될까?
Home - SCIENCE WAVE사이언스 웨이브(Science Wave)는 과학의 눈으로 세상을 바라봅니다. 최신 과학뉴스와 쉽고 재미있는 과학상식을 전달합니다.sciencewave.kr 눈물이 흘러내릴 수 없을 만큼 중력이 약한
sciencewave.tistory.com
'과학 상식' 카테고리의 다른 글
| [티라노사우루스] <쥬라기 월드>에서 등장한 모사사우루스는 너무 크다 (0) | 2025.03.12 |
|---|---|
| 원소 황(黃)과 황산의 성질과 이용도 (0) | 2025.03.12 |
| 뒤뚱거리지만 넘어지지 않는 펭귄의 비밀 (0) | 2025.03.12 |
| 왜 자철광만 자력을 가졌나? (0) | 2025.03.12 |
| [세계 수학사 中] 유클리드의 '원론' (0) | 2025.03.10 |